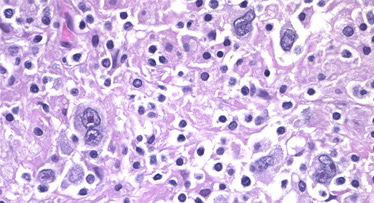

Запись на ПЭТ/КТ за счет личных средств и по ОМС
Специальная цена на проведение ПЭТ/КТ-исследования, скидки от 10%

Запись на ПЭТ/КТ за счет личных средств
Записаться платноЗапись на ПЭТ/КТ по ОМС
Записаться по ОМСНа карте
Ближайшие центры
Центры 14
Центр лучевой терапии «ПЭТ-Технолоджи» в Омске на Завертяевой улице
Омская область, г. Омск, ул. Завертяева, д. 9, корпус 1
+7 (3812) 72-98-81
ПН – ПТ: 08:00 – 20:00
Центр «ПЭТ-Технолоджи» в Обнинске

Калужская область, г. Обнинск, ул. Королева, д.4, здание №4
+7 (484) 290-80-51
ПН – ПТ: 08:00 – 17:00
Центр лучевой терапии «ПЭТ-Технолоджи» в Новосибирске на Залесского
Новосибирская область, г. Новосибирск, ул. Залесского, д.6, корпус 5
+7 (383) 252-05-09
ПН – ПТ: 08:00 – 22:00, СБ – ВС – выходной
Центр «ПЭТ-Технолоджи» в Москве на Профсоюзной улице
г. Москва, ул. Профсоюзная, д. 86, стр. 3
+7 (495) 011-00-88
ПН – ПТ: 07:00 – 16:00
Центр «ПЭТ-Технолоджи» в Москве на Оршанской улице

г. Москва, ул. Оршанская, д. 16, стр. 11
+7 (495) 011-00-88
ПН – ПТ: 07:00 – 16:00
Центр «ПЭТ-Технолоджи» в Курске
Курская область, г. Курск, ул. Дружбы, д. 4
+7 (4712) 90-03-03
ПН – ПТ: 08:00 – 17:00
Центр «ПЭТ-Технолоджи» в Краснодаре на улице 1 Мая
Краснодарский край, г. Краснодар, ул. 1-го Мая, д. 167
+7 (861) 992-32-52
ПН – ВС: 07:00 – 19:00
Центр «ПЭТ-Технолоджи» в Кирове

Кировская область, г. Киров, проспект Строителей, д. 23
+7 (8332) 49-70-75
ПН – ПТ 07:00 – 16:00. СБ – ВС – выходной
Центр «ПЭТ-Технолоджи» в Ижевске

Удмуртская Республика, г. Ижевск, ул. Труда, д. 1, Литер «Р»
+7 (3412) 27-71-21
ПН – ПТ: 07:00 – 16:00, СБ – ВС – выходной
Центр «ПЭТ-Технолоджи» в Екатеринбурге

Свердловская область, г. Екатеринбург, ул. Соболева, д. 29, стр. 8
+7 (343) 224-82-34
Время работы
ПН – ПТ: 08:00 – 16:00, СБ – ВС – выходной
Центр «ПЭТ-Технолоджи» во Владимире

Владимирская область, г. Владимир, Судогодское ш., д. 39-Ж
+7 (492) 247-50-00
ПН-ВС: 07:30 – 20:00
Центр «ПЭТ-Технолоджи» в Брянске

Брянская область, г. Брянск, пр-кт Станке Димитрова, д. 84Б
+7 (4832) 44-08-38
ПН – ПТ: 08:00 – 17:00
Европейская аккредитация качества ПЭТ/КТ-сканирования

143900, Московская область, г. Балашиха, ул. Карбышева, д. 6Б
+7 (495) 011-00-88
Амбулаторно-поликлиническое отделение:
без выходных 07:30 - 22:00
Стационарное отделение:
круглосуточно и без выходных
Центр «ПЭТ-Технолоджи» в Белгороде

Белгородская область, г. Белгород, ул. Куйбышева, д. 2А
+7 (4722) 77-71-00
ПН – ПТ: 08:00 – 17:00, СБ – ВС: выходной
Популярные услуги
11 направлений, включая ПЭТ / КТ и КиберНож
Онлайн-консультация

Дистанционные видеоконсультации с нашими ведущими врачами-экспертами «ПЭТ-Технолоджи» в области онкологии и радиотерапии.
Записаться Подробнее об услугеПересмотр заключения

Если вы сомневаетесь в трактовке результатов ПЭТ/КТ, ПЭТ/МРТ, КТ, МРТ. Воспользуйтесь нашей услугой повторного описания исследований.
Записаться Подробнее об услугеПЭТ/КТ-диагностика

Современный метод диагностики онкологических заболеваний, сочетающий позитронно-эмиссионную и компьютерную томографию.
Записаться Подробнее об услугеМРТ-Диагностика

МРТ (магнитно-резонансная томография) - современный неинвазивный метод диагностики, который основан на поглощении электромагнитной энергии организмом человека.
Записаться Подробнее об услугеКТ-Диагностика

КТ (компьютерная томография) - один из наиболее информативных и современных методов лучевой диагностики широкого списка заболеваний.
Записаться Подробнее об услугеУльтразвуковое исследование

УЗИ является необходимым звеном в онкологической службе и представляет собой недорогой высокоинформативный, неинвазивный и безопасный метод лучевой диагностики.
Записаться Подробнее об услугеОФЭКТ/КТ и сцинтиграфия

Современный гибридный метод исследования, позволяющий определить очаги распространения онкологических заболеваний, а также выявить структурные изменения и функциональные нарушения ряда систем организма.
Записаться Подробнее об услугеЛучевая терапия

Один из трех главных методов лечения пациентов с опухолевыми (онкологическими) заболеваниями, который заключается в воздействии на опухоль ионизирующим излучением – радиацией
Записаться Подробнее об услугеХимиотерапия

Химиотерапия –это эффективное лечение онкологических заболеваний с помощью лекарственных препаратов. Их действие направлено на деструкцию и блокировку роста опухолевых клеток.
Записаться Подробнее об услугеЛечение КиберНожом

Система КиберНож - альтернатива хирургической операции в лечении многих онкологических заболеваний. Проводится без воздействия на кожный покров пациента
Записаться Подробнее об услугеФизиотерапия

Метод лечения с использованием низкоинтенсивного лазерного излучения для целенаправленного воздействия на зону поражения.
Записаться Подробнее об услугеКогда будут результаты?
Тип исследования
Срок готовности
Город
Лучевая терапия
1-5 рабочих дней
Москва
КиберНож
1-5 рабочих дней
Москва
Химиотерапия
1-5 рабочих дней
Москва
Физиотерапия
1-5 рабочих дней
Москва
Качество, оборудование, стандартизация
Наши врачи
О враче

Алхимова Татьяна Александровна
Руководитель обособленного подразделения
Место работы (ДЦ)
Центр «ПЭТ-Технолоджи» в Брянске
График работы и часы приема
Ср-Ср с 12:00 до 14:00 Пт-Пт с 10:00 до 12:00
О враче

Знаменский Сергей Александрович
Руководитель обособленного подразделения
О враче

Ушакова Оксана Валентиновна
Руководитель обособленного подразделения
О враче

Коновалов Артём Игоревич
Главный врач, Врач-онколог, радиотерапевт
О враче

Князева Ярослава Валерьевна
Главный врач
О враче

Тулина Лариса Михайловна
Главный врач
О враче

Андронов Андрей Витальевич
Главный врач
О враче

Шаталов Александр Геннадьевич
Главный врач
О враче

Шевченко Сергей Михайлович
Главный врач
О враче

Аладин Александр Сергеевич
Главный врач
О враче

Коновалов Олег Вениаминович
Главный врач
О враче

Мананников Александр Васильевич
Главный врач, Врач-радиотерапевт
О враче

Недерова Мария Александровна
Главный врач, Врач-радиотерапевт
О враче

Кочуев Сергей Сергеевич
Главный врач, Врач-онколог
О враче

Волков Александр Александрович
Главный врач, Врач-онколог
О враче

Андрианов Анатолий Станиславович
Главный врач
О враче

Тугунов Иван Юрьевич
Главный врач
О враче

Соловьев Денис Вячеславович
Главный врач
Отзывы пациентов
Новости

В Ростове-на-Дону открылся второй центр ПЭТ/КТ-диагностики «ПЭТ-Технолоджи»
26.12.2022
Читать статью

Эксперты «ПЭТ-Технолоджи» на III Весеннем онкологическом онлайн-марафоне «ONLINE-ВЕСНА»
26.12.2022
Читать статью

Специалисты «ПЭТ-Технолоджи» рассказали о возможностях ядерной медицины в клинической онкологии
26.12.2022
Читать статью



ПЭТ-Технолоджи Балашиха приглашает пациентов с раком шейки матки принять участие в клиническом исследовании препарата
27.12.2022
Читать статью


Знание и контроль за опухолями – первые месяцы работы Центра ядерной медицины в Белгороде
27.12.2022
Читать статью

Производство «ПЭТ-Технолоджи» соответствует правилам надлежащей производственной практики
27.12.2022
Читать статью


Первая дата: ровно год назад начал свою работу центр ядерной медицины «ПЭТ-Технолоджи» на Оршанской
26.12.2022
Читать статью

Александр Панкратов: «Врач должен использовать любую возможность помочь пациенту»
27.12.2022
Читать статью

Сергей Двойников: «Раньше мы знали опухоль только по имени, а сейчас определяем имя, отчество, фамилию, домашний адрес и номер телефона»
27.12.2022
Читать статью

Интервью с Валерием Ивановым: «У онколога есть радость видеть выздоровевшего пациента»
27.12.2022
Читать статью

В центре ПЭТ-Технолоджи Балашиха можно получить бесплатное лечение плоскоклеточного рака шейки матки новым препаратом
26.12.2022
Читать статью

Мастер-класс по лучевой терапии в рамках Российского конгресса по колоректальному раку 2021
26.12.2022
Читать статью
Конференция «Олигометастазы и повторное облучение: новые горизонты в радиотерапии»
27.12.2022
Читать статью




Специалисты «ПЭТ-Технолоджи» провели круглый стол «Новые стандарты лучевой и инструментальной диагностики»
26.12.2022
Читать статью





Онколог и рентгенолог: мультидисциплинарный подход в оценке опухолевого процесса
27.12.2022
Читать статью

Интервью с Сергеем Двойниковым: «Мы заботимся о том, чтобы нашим пациентам было комфортно и не страшно»
27.12.2022
Читать статью





Интервью с Мариной Григорьевой: «Мы гарантируем пациентам эффективность и качество препаратов»
27.12.2022
Читать статью

Интервью с Ольгой Ушаковой: «Чтобы справиться с болезнью, надо найти смысл жизни»
26.12.2022
Читать статью



Врачи ПЭТ-Технолоджи Балашиха приняли участие в III съезде онкологов Московской области
26.12.2022
Читать статью

Интервью с Денисом Королевым: «Методы лучевой диагностики хороши, когда дополняют друг друга»
27.12.2022
Читать статью



Интервью с Журавлевой Олесей Петровной: «Женщина требует повышенного внимания»
26.12.2022
Читать статью

Центр ядерной медицины в Рязани стал центром компетенций для студентов-медиков
26.12.2022
Читать статью


Специалисты Группы компаний «МедИнвестГрупп» выступили на конференции «Радиофарма-2021»
27.12.2022
Читать статью

Экспертиза «ПЭТ-Технолоджи» в фокусе профессионального сообщества на конгрессе «Ядерная медицина-2025»
19.12.2025
Читать статью
Специалисты «ПЭТ-Технолоджи» выступили на Первом Московском международном конгрессе по ядерной медицине
11.12.2025
Читать статью
Интервью с Марьям Рамазановой: «Ядерная медицина – незаменимый помощник доктора для проведения диагностики и лечения…»
27.12.2022
Читать статью


Роль ПЭТ/КТ в нейровизуализации: доклад главного радиолога «ПЭТ-Технолоджи» на Осенней школе невролога
11.12.2025
Читать статью


«ПЭТ-Технолоджи» на Конгрессе РОРР-2025: экспертный вклад в развитие медицинской визуализации
21.11.2025
Читать статью
Российская вакцина от рака: экспертное мнение ведущего онколога «ПЭТ-Технолоджи»
07.11.2025
Читать статью


Главная медицинская сестра Центра «ПЭТ-Технолоджи» Балашиха выступила на конференции «Волжские огни VIII»
07.11.2025
Читать статью

Интервью с Юлией Евдокимовой: «Химиотерапия – молодая и перспективная наука»
27.12.2022
Читать статью

Конференция к 80-летию Ставропольского онкодиспансера: «ПЭТ-Технолоджи» — генеральный партнёр события
01.11.2025
Читать статью
Эксперт «ПЭТ-Технолоджи» на встрече Фонда Хабенского о стандартизации результатов ПЭТ/КТ в нейроонкологии
31.10.2025
Читать статью


«ПЭТ-Технолоджи» на IV Поволжском онкологическом форуме: региональный опыт и новые решения
17.10.2025
Читать статью
Эксперты «ПЭТ-Технолоджи» представили доклады на Российском диагностическом саммите 2025
16.10.2025
Читать статью
Специалисты «ПЭТ-Технолоджи» делятся опытом на 5 съезде Национального общества нейрорадиологов
26.12.2022
Читать статью

Специалисты сестринской службы «ПЭТ-Технолоджи» выступили на симпозиуме в Москве
13.10.2025
Читать статью

Интервью с Ириной Страдаевой: «Задача всегда одна: найти лучший вариант лечения»
28.12.2022
Читать статью

Будущее онкодиагностики: «ПЭТ-Технолоджи» на VI форуме «Инновационная онкология»
18.09.2025
Читать статью

Специалисты «ПЭТ-Технолоджи» провели прекурс по лучевой терапии в рамках форума «Инновационная онкология»
26.12.2022
Читать статью

Пациент в центре внимания: «ПЭТ-Технолоджи» о культуре безопасности на форуме «Белые ночи»
25.07.2025
Читать статью
ПЭТ/КТ в фокусе: доклад «ПЭТ-Технолоджи» на научно-практической конференции в Абакане
08.07.2025
Читать статью


Участие «ПЭТ‑Технолоджи» в Нейрофоруме‑2025: ПЭТ/КТ в неврологической практике
11.07.2025
Читать статью
ПЭТ/КТ и персонализация лечения: опыт «ПЭТ-Технолоджи» на Московском онкологическом форуме 2025
07.07.2025
Читать статью
Интервью с Мариной Трушковой: «Онкология переходит в разряд хронических заболеваний…»
28.12.2022
Читать статью



Интервью с Кариной Королевой: «Главное для онколога – клиническое мышление…»
28.12.2022
Читать статью

Научное лидерство в действии: компания «ПЭТ-Технолоджи» стала организатором конференции о современных подходах в онкологии
12.06.2025
Читать статью

Центр лучевой терапии в Екатеринбурге провел более 38 тысяч сеансов за год работы
26.12.2022
Читать статью



Новый диагностический центр «ПЭТ-Технолоджи» во Владимире сегодня принял первого пациента
26.12.2022
Читать статью


«ПЭТ-Технолоджи» о ПЭТ/КТ с 18F-DOPA: делимся опытом на неврологических конференциях в Москве
25.04.2025
Читать статью
Не только онкология: специалисты «ПЭТ-Технолоджи» рассказали врачам Перми о широких возможностях лучевой диагностики
26.12.2022
Читать статью

Участие «ПЭТ-Технолоджи» в Невском радиологическом форуме – 2025: новые вызовы и решения в визуализации онкопатологий
18.04.2025
Читать статью
ПЭТ/КТ с PSMA: как повысить точность интерпретации — опыт эксперта «ПЭТ-Технолоджи» на форуме в Махачкале
17.04.2025
Читать статью






Сегодня исполнилось 3 года со дня начала работы Онкорадиологического центра ПЭТ-Технолоджи в Балашихе
28.12.2022
Читать статью

Форум онкологов Сибири и Дальнего Востока в Новокузнецке 13-14 марта 2025 года
31.03.2025
Читать статью
13 марта эксперты ПЭТ-Технолоджи приняли участие в конференции RUSSCO «Рак легкого и опухоли средостения»
28.12.2022
Читать статью

Всероссийский конкурс кадрового резерва «ПЭТ-кадры» для молодых специалистов в области ядерной медицины
12.03.2025
Читать статью
Эксперты ПЭТ-Технолоджи на II Весеннем онкологическом онлайн-марафоне «ONLINE-ВЕСНА»
26.12.2022
Читать статью


Специалисты ПЭТ-Технолоджи на IV Всероссийском научно-образовательном конгрессе с международным участием «Онкорадиология, лучевая диагностика и терапия»
28.12.2022
Читать статью

Запуск ПЭТ/КТ с 18F-ТИРОЗИНОМ(ФЭТ) в центре «ПЭТ-Технолоджи» ПМГУ им. Сеченова
13.02.2025
Читать статью
Во Владимире открыт центр ядерной медицины для диагностики онкологический заболеваний «ПЭТ-Технолоджи»
26.12.2022
Читать статью










Летняя практика в «ПЭТ-Технолоджи» — найди свое профессиональное «я» в онкологии или радиологии
11.06.2024
Читать статью
20 ноября 2020 года новый диагностический центр «ПЭТ-Технолоджи» в Москве принял первого пациента
26.12.2022
Читать статью

Рак предстательной железы. Диагностировать нельзя упустить - расставляем запятые на вебинаре с онкоурологом Рустемом Гафановым
07.06.2024
Читать статью


Специалисты «ПЭТ-Технолоджи» поделились опытом применения канцеркалькуляторов на отраслевой конференции в Пятигорске
23.05.2024
Читать статью
9 ноября центр ядерной медицины «ПЭТ-Технолоджи» в Астрахани начал принимать первых пациентов на ПЭТ/КТ-диагностику
26.12.2022
Читать статью




Объявлены победители Всероссийского конкурса среди рентгенологов и радиологов «ПЭТ-кадры»
02.05.2024
Читать статью



Специалисты «ПЭТ-Технолоджи» на Осеннем онкологическом марафоне «ONLINE-ОСЕНЬ»
26.12.2022
Читать статью

Реальные кейсы лечения онкозаболеваний при поддержке ПЭТ/КТ обсудили участники конференции в Москве
11.04.2024
Читать статью


Опыт химиолучевой терапии в лечении рака пищевода в центре «ПЭТ-Технолоджи Подольск» обсудили на Форуме онкологов ЦФО
02.04.2024
Читать статью


Объединяя усилия: «круглые столы» с участием онкологов и радиологов состоялись в 4 регионах РФ на базе центров «ПЭТ-Технолоджи»
29.03.2024
Читать статью
Новые рекомендации по лучевой терапии лимфомы Ходжкина: успехи ПЭТ/КТ и снижение побочных эффектов
27.12.2022
Читать статью
3 эксперта «ПЭТ-Технолоджи» на Международном конгрессе в Уфе по онкоурологии 21-23 марта
26.03.2024
Читать статью


Эксперты «ПЭТ-Технолоджи» собрали 10 аргументов в пользу профессии «радиолог»
22.03.2024
Читать статью
Специалисты «ПЭТ-Технолоджи» на Всероссийском онкологическом Конгрессе «Крымский прибой»
26.12.2022
Читать статью

Летние стажировки в «ПЭТ-Технолоджи» — твой решительный шаг навстречу карьере
21.03.2024
Читать статью
9 сентября прошел вебинар «Роль лучевой терапии в лечении онкологических заболеваний»
28.12.2022
Читать статью
ПЭТ/КТ позволяет с высокой точностью прогнозировать выживаемость при раке молочной железы
27.12.2022
Читать статью
Играем против времени: проблемы иммуноонкологии обсуждали специалисты на конференции RUSSCO в Москве
18.03.2024
Читать статью




ПЭТ/КТ с ФДГ – стопроцентная точность в диагностике метастазов почечноклеточного рака
27.12.2022
Читать статью
Эксперты рассказали о применении лазеротерапии в реабилитации онкологических пациентов
14.03.2024
Читать статью
Интервью Главного врача «ПЭТ-Технолоджи Подольск» Марины Васильевны Черных журналу Американского общества клинической онкологии ASCO
28.12.2022
Читать статью





В начале августа 2020 откроет двери новый центр лучевой терапии ПЭТ-Технолоджи В Екатеринбурге
26.12.2022
Читать статью
Применение КиберНожа повышает остроту зрения при лечении периоптических менингиом
27.12.2022
Читать статью
Врачи Онкорадиологического центра «ПЭТ-Технолоджи» в Балашихе встретились с онкологами Областной больницы
26.02.2024
Читать статью
В онкорадиологическом центре ПЭТ-Технолоджи в Балашихе появился новый метод ПЭТ/КТ с использованием 18F-ПСМА
26.12.2022
Читать статью

Врач-радиотерапевт «ПЭТ-Технолоджи» читает лекцию об облегчении боли онкологическим пациентам
15.02.2024
Читать статью
В онкорадиологическом центре ПЭТ-Технолоджи в Балашихе появился новый метод ПЭТ/КТ с использованием 18F-Фторэтилтирозина
26.12.2022
Читать статью
Встреча Президента РФ В.В.Путина с председателем правления ОАО «РОСНАНО» А.Б.Чубайсом
27.12.2022
Читать статью



Отмечаем 2 года со дня открытия центра лучевой терапии «ПЭТ-Технолоджи» в Омске
09.02.2024
Читать статью
Вебинар «Диагностика и лечение злокачественных новообразований головы и шеи»
26.12.2022
Читать статью

В Казахстане состоялись круглые столы с участием российских специалистов «ПЭТ-Технолоджи»
26.01.2024
Читать статью


Радиотерапевт Онкорадиологического центра Балашихи читает лекцию на курсе ISRS в Стамбуле
22.12.2023
Читать статью
В пятницу, 22 мая в 12:00 приглашаем вас на вебинар «Диагностика и лечение колоректального рака»
26.12.2022
Читать статью

Специалисты Онкорадиологического центра города Уфы поделились опытом лечения рака легких с онкологами Башкортостана
08.12.2023
Читать статью



Врачи рассказали, как людям с ослабленным иммунитетом вести себя во время пандемии
26.12.2022
Читать статью

Итоги премии ПроДокторов 2023: Центр «ПЭТ-Технолоджи» в Астрахани в числе лучших
02.11.2023
Читать статью



Генеральный директор центров в Балашихе и Подольске Сергей Двойников дал интервью в эфире «Здоровый разговор»
26.12.2022
Читать статью
Эксперты «ПЭТ-Технолоджи» поделились опытом на II Евразийском конгрессе урологов в Уфе
20.03.2023
Читать статью

14 апреля прошел бесплатный вебинар «Организация медицинской помощи для онкопациента»
27.12.2022
Читать статью

В Онкорадиологическом центре ПЭТ-Технолоджи в Подольске прошел мастер-класс по применению МРТ диагностики эпилепсии
05.07.2023
Читать статью
В четверг, 30 апреля с 17 до 19 приглашаем вас на вебинар «Рак легкого: диагностика, лечение и возвращение к обычной жизни»
27.12.2022
Читать статью


В понедельник, 27 апреля в 11:00 приглашаем вас на вебинар «ПЭТ/КТ в онкодиагностике: что нужно знать пациенту»
27.12.2022
Читать статью
Более 7 700 человек прошли высокоточную диагностику онкопатологии методом ПЭТ/КТ в Владимире
21.06.2023
Читать статью



20 июня состоится прием первых пациентов в Центре Ядерной медицины на территории ПМГМУ И.М. Сеченова
13.06.2023
Читать статью
III Всероссийский научно-образовательный конгресс «Онкорадиология, лучевая диагностика и терапия»
27.12.2022
Читать статью




Конференция «День онколога» по теме: «Вопросы онкоурологии в Новосибирской области» 02.03.2023г.
02.03.2023
Читать статью
Центр «ПЭТ-Технолоджи» в Тамбове – победитель Всероссийского конкурса «Лучший проект государственно-частного взаимодействия»
27.12.2022
Читать статью





Ведущий эксперт «ПЭТ-Технолоджи» рассказал о правилах ранней диагностики онкозаболеваний
27.12.2022
Читать статью
Эксперты ПЭТ-Технолоджи провели конференцию для рязанских онкологов, посвященную методу ПЭТ-КТ
13.03.2023
Читать статью

Итоги премии «ПроДокторов 2022»: «ПЭТ-Технолоджи Астрахань» в числе лучших частных клиник области
26.12.2022
Читать статью
В Онкорадиологических центрах Подмосковья можно получить паллиативную помощь за 3 часа
27.12.2022
Читать статью
В Обнинске прошла Молодежная региональная конференция для студентов, ординаторов и молодых ученых
20.12.2022
Читать статью

Ведущий эксперт ПЭТ-Технолоджи рассказал о возможностях радиофармацевтики на ММИФ-2022
26.12.2022
Читать статью

Сергей Юрьевич Абашин рассказал о возможностях метода ПЭТ/КТ для гематологов из пяти столиц
26.12.2022
Читать статью
Специалисты ПЭТ-Технолоджи рассказали о диагностике злокачественных новообразований в Саратовском онкодиспансере
27.12.2022
Читать статью

Член комитета Совета Федерации посетил центр ""ПЭТ-Технолоджи"" в г. Тамбов
27.12.2022
Читать статью


Специалисты «ПЭТ-Технолоджи» на Конгрессе Российского общества рентгенологов и радиологов
26.12.2022
Читать статью
Центры ""ПЭТ-Технолоджи"" в Самаре и Тольятти – лучшие частные медицинские организации Самарской области.
27.12.2022
Читать статью

Павел Решетник, врач-рентгенолог, радиолог Курского центра «ПЭТ-Технолоджи» принял участие в ХI международном конгрессе ""Невский Радиологический Форум - 2019"".
27.12.2022
Читать статью
В ИвГМА прошла Молодежная региональная конференция для студентов, ординаторов и молодых специалистов
26.12.2022
Читать статью
«ПЭТ-Технолоджи» приняли участие в научно-практической конференции региональной общественной организации «Ассоциация практических онкологов Белгородской области»
27.12.2022
Читать статью


В Нижнем Новгороде прошла Молодежная региональная конференция для студентов, ординаторов и молодых специалистов
26.12.2022
Читать статью
Центр ядерной медицины в Екатеринбурге будет принимать в два раза больше пациентов
27.12.2022
Читать статью

Сотрудники центра «ПЭТ-Технолоджи» Подольск провели мастер-класс и круглый стол в рамках конференции RUSSCO
27.12.2022
Читать статью
Межрегиональная юбилейная научно-практическая онкологическая конференция «Волжские огни V»
26.12.2022
Читать статью
В Вене прошел юбилейный 25-й конгресс Европейского Общества Радиологов (ESR). Профессор Валентин Евгеньевич Синицын награжден золотой медалью.
27.12.2022
Читать статью



«ПЭТ-Технолоджи» запустила производство нового препарата для диагностики рака простаты
27.12.2022
Читать статью

Онкорадиологический центр в Балашихе посетили Черкасов Николай Иванович и Татевосян Лилия Набиулловна
28.12.2022
Читать статью


Делимся опытом с коллегами на форумах «Инновационная онкология» и РОСМЕДОБР 2022
26.12.2022
Читать статью






В сети центров «ПЭТ-Технолоджи» внедрены международные стандарты применения новых радиофармпрепаратов
27.12.2022
Читать статью


«Мед_Пикник» прошел в последнюю субботу уходящего лета для медицинских специалистов Новосибирской области
26.12.2022
Читать статью
Впервые в России — новые возможности планирования лечения на системе КиберНож
27.12.2022
Читать статью
Александр Евгеньевич Николаев на 28-ой конгрессе Европейского общества радиологов
26.12.2022
Читать статью


Губернатор Самарской области открыл первый центр ядерной медицины в регионе
27.12.2022
Читать статью

Сотрудники «ПЭТ-Технолоджи» приняли участие в конференции производителя оборудования для ядерной медицины
27.12.2022
Читать статью
XIII Съезд онкологов и радиологов стран СНГ и Евразии: Телемедицинские аспекты
26.12.2022
Читать статью
Сотрудники «ПЭТ-Технолоджи» приняли участие в съезде «Общества ядерной медицины»
27.12.2022
Читать статью

Депутаты Государственного Собрания Башкортостана посетили уфимский ПЭТ-центр
27.12.2022
Читать статью



Визит представителей компании «ПЭТ-Технолоджи» в онкологический центр им. Слоуна-Кеттеринга
27.12.2022
Читать статью
Медицина в лицах: знакомимся с главным врачом центра лучевой терапии «ПЭТ-Технолоджи» Марией Недеровой
26.12.2022
Читать статью

Эксперт «ПЭТ-Технолоджи» рассказал онкологам про диагностические возможности ПЭТ/КТ при раке молочной железы
26.12.2022
Читать статью
Контакты
Центр телемедицины
Адрес телемедицины
г. Москва, ул. Центральная, д. 1
График работы:
Пн-Вт
Время работы:
10:00 — 18:00
Партнеры

Сеть клиник К+31
Современная многопрофильная клиника с европейскими стандартами лечения и сервиса

Клиники Лядова
Реабилитация пациентов с онкологическими заболеваниями, восстановление после инсульта















